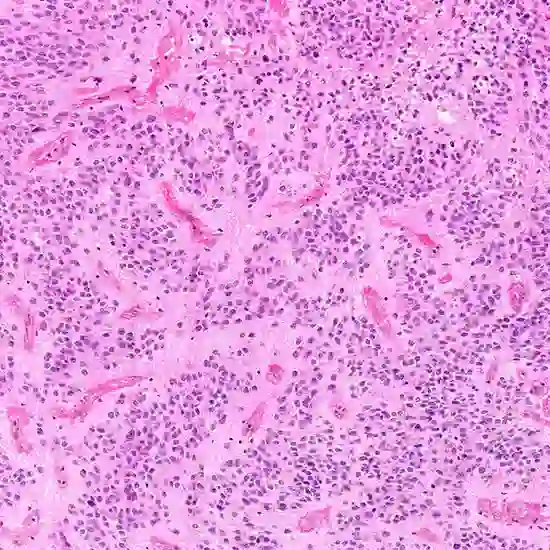
ependymoma

Book Ependymoma Appointment Online Near me at the best price in Delhi/NCR from Ganesh Diagnostic. NABL & NABH Accredited Diagnostic centre and Pathology lab in Delhi offering a wide range of Radiology & Pathology tests. Get Free Ambulance & Free Home Sample collection. 24X7 Hour Open. Call Now at 011-47-444-444 to Book your Ependymoma at 50% Discount.
Ependymoma is a type of brain tumor that originates from the ependymal cells, which are specialized cells that line the ventricles (fluid-filled spaces) of the brain and the central canal of the spinal cord. Ependymomas are typically classified as a type of glioma, as they arise from glial cells in the brain.
Ependymomas occurs at any age, but most commonly diagnosed in children and young adults. They can be located in various parts of the brain, including the ventricles, spinal cord, and other areas.
| CT Brain | 1250 | |
| MRI Spinal Cord | 4000 | |
| MRI Brain | 4000 | |
| Brain PET Scan | 11950 | |
| Total Price | 21200 |
Ependymomas are classified into different grades based on their aggressiveness and appearance under a microscope, according to the World Health Organization (WHO) grading system.
| Test Type | Ependymoma |
| Includes | Ependymoma (Common Diseases) |
| Preparation | |
| Reporting | Within 24 hours* |
| Test Price |
₹ 21200
|

Early check ups are always better than delayed ones. Safety, precaution & care is depicted from the several health checkups. Here, we present simple & comprehensive health packages for any kind of testing to ensure the early prescribed treatment to safeguard your health.